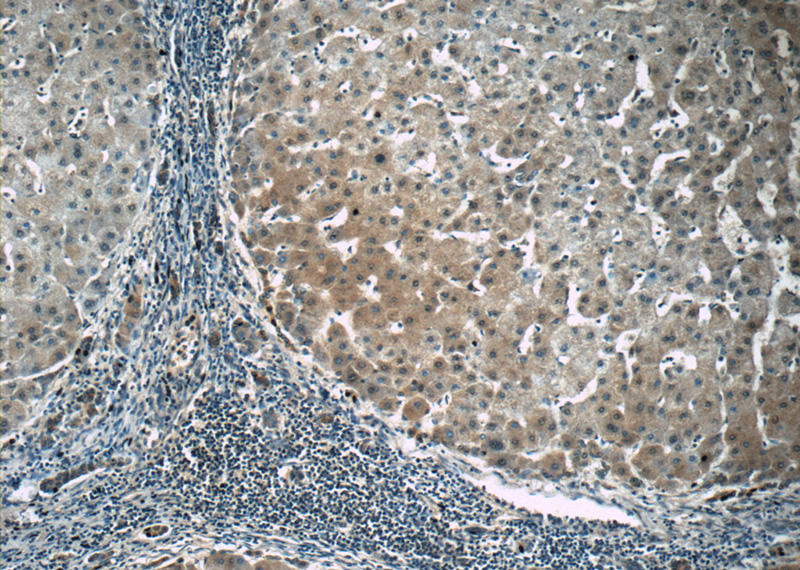
Immunohistochemistry of paraffin-embedded human hepatocirrhosis tissue slide using Catalog No:113784(PGK1 Antibody) at dilution of 1:50 (under 10x lens)

-
Product Name
PGK1 antibody
- Documents
-
Description
PGK1 Rabbit Polyclonal antibody. Positive IHC detected in human hepat℃irrhosis tissue. Positive WB detected in HeLa cells, A431 cells, HEK-293 cells, HepG2 cells, human stomach tissue, mouse brain tissue, PC-3 cells. Observed molecular weight by Western-blot: 40-45 kDa
-
Tested applications
ELISA, WB, IHC
-
Species reactivity
Human, Mouse; other species not tested.
-
Alternative names
MIG10 antibody; OK/SW cl.110 antibody; PGK1 antibody; PGKA antibody; phosphoglycerate kinase 1 antibody; Primer recognition protein 2 antibody; PRP 2 antibody
-
Isotype
Rabbit IgG
-
Preparation
This antibody was obtained by immunization of PGK1 recombinant protein (Accession Number: NM_000291). Purification method: Antigen affinity purified.
-
Clonality
Polyclonal
-
Formulation
PBS with 0.02% sodium azide and 50% glycerol pH 7.3.
-
Storage instructions
Store at -20℃. DO NOT ALIQUOT
-
Applications
Recommended Dilution:
WB: 1:500-1:5000
IHC: 1:20-1:200
-
Validations

HeLa cells were subjected to SDS PAGE followed by western blot with Catalog No:113784(PGK1 antibody) at dilution of 1:1200
Immunohistochemistry of paraffin-embedded human hepatocirrhosis tissue slide using Catalog No:113784(PGK1 Antibody) at dilution of 1:50 (under 10x lens)

Immunohistochemistry of paraffin-embedded human hepatocirrhosis tissue slide using Catalog No:113784(PGK1 Antibody) at dilution of 1:50 (under 40x lens)
-
Background
The PGK1 gene encodes phosphoglycerate kinase-1, also known as ATP:3-phosphoglycerate 1-phosphotransferase (EC 2.7.2.3), which catalyzes the reversible conversion of 1,3-diphosphoglycerate to 3-phosphoglycerate during glycolysis, generating one molecule of ATP. It Belongs to the phosphoglycerate kinase family and defects in PGK1 are the cause of phosphoglycerate kinase 1 deficiency (PGK1D).
-
References
- Yu Y, Pan X, Ding Y. An iTRAQ based quantitative proteomic strategy to explore novel secreted proteins in metastatic hepatocellular carcinoma cell lines. The Analyst. 138(16):4505-11. 2013.
- Ma X, Li C, Sun L. Lin28/let-7 axis regulates aerobic glycolysis and cancer progression via PDK1. Nature communications. 5:5212. 2014.
- Sun L, Song L, Wan Q. cMyc-mediated activation of serine biosynthesis pathway is critical for cancer progression under nutrient deprivation conditions. Cell research. 25(4):429-44. 2015.
- Isnard A, Christian JG, Kodiha M, Stochaj U, McMaster WR, Olivier M. Impact of Leishmania infection on host macrophage nuclear physiology and nucleopore complex integrity. PLoS pathogens. 11(3):e1004776. 2015.
Related Products / Services
Please note: All products are "FOR RESEARCH USE ONLY AND ARE NOT INTENDED FOR DIAGNOSTIC OR THERAPEUTIC USE"
